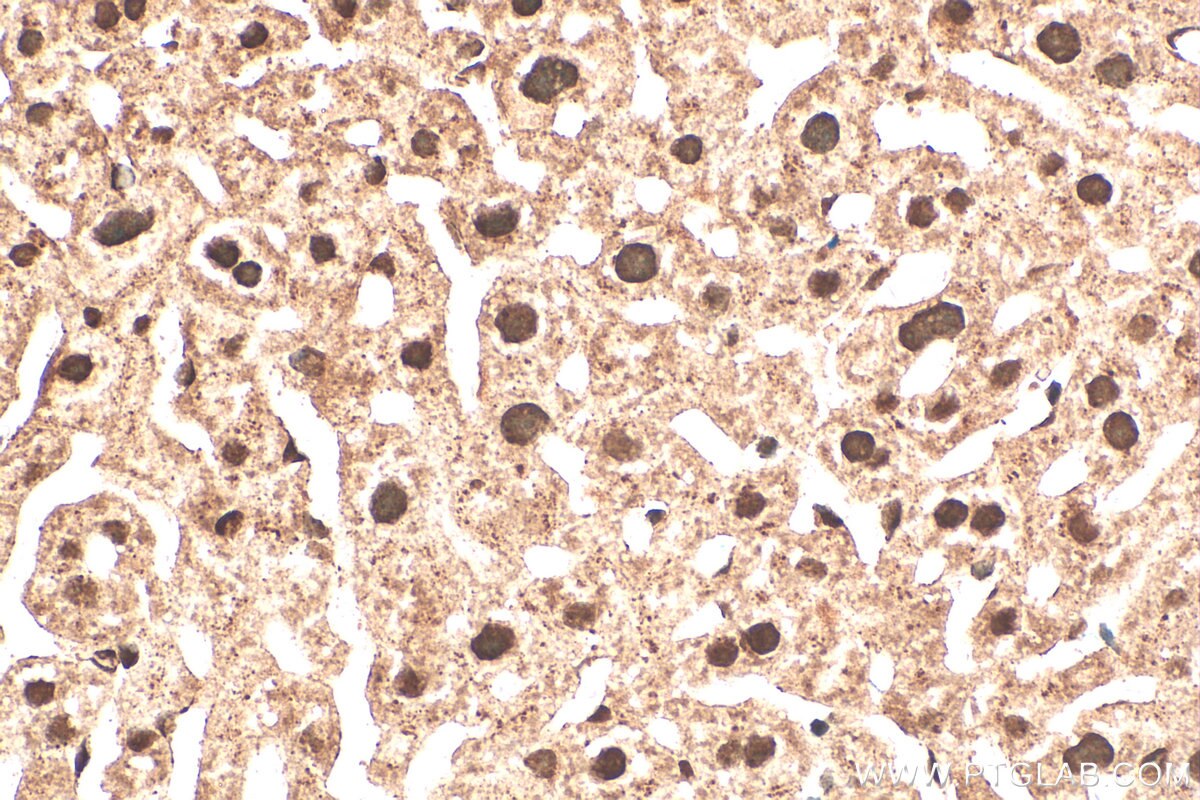
Immunohistochemistry (IHC) staining of mouse liver tissue using NEK6 Polyclonal antibody (28070-1-AP)

Validation Data Gallery
Tested Applications
| Positive WB detected in | mouse liver tissue, rat liver tissue |
| Positive IHC detected in | rat liver tissue, mouse liver tissue Note: suggested antigen retrieval with TE buffer pH 9.0; (*) Alternatively, antigen retrieval may be performed with citrate buffer pH 6.0 |
| Positive IF/ICC detected in | HeLa cells |
Recommended dilution
| Application | Dilution |
|---|---|
| Western Blot (WB) | WB : 1:500-1:2000 |
| Immunohistochemistry (IHC) | IHC : 1:50-1:500 |
| Immunofluorescence (IF)/ICC | IF/ICC : 1:50-1:500 |
| It is recommended that this reagent should be titrated in each testing system to obtain optimal results. | |
| Sample-dependent, Check data in validation data gallery. | |
Product Information
28070-1-AP targets NEK6 in WB, IHC, IF/ICC, ELISA applications and shows reactivity with human, mouse, rat samples.
| Tested Reactivity | human, mouse, rat |
| Host / Isotype | Rabbit / IgG |
| Class | Polyclonal |
| Type | Antibody |
| Immunogen |
CatNo: Ag27887 Product name: Recombinant human NEK6 protein Source: e coli.-derived, PET28a Tag: 6*His Domain: 174-313 aa of BC000101 Sequence: KPANVFITATGVVKLGDLGLGRFFSSETTAAHSLVGTPYYMSPERIHENGYNFKSDIWSLGCLLYEMAALQSPFYGDKMNLFSLCQKIEQCDYPPLPGEHYSEKLRELVSMCICPDPHQRPDIGYVHQVAKQMHIWMSST 相同性解析による交差性が予測される生物種 |
| Full Name | NIMA (never in mitosis gene a)-related kinase 6 |
| Calculated molecular weight | 35 kDa |
| Observed molecular weight | 35-40 kDa |
| GenBank accession number | BC000101 |
| Gene Symbol | NEK6 |
| Gene ID (NCBI) | 10783 |
| RRID | AB_3742272 |
| Conjugate | Unconjugated |
| Form | |
| Form | Liquid |
| Purification Method | Antigen affinity purification |
| UNIPROT ID | Q9HC98 |
| Storage Buffer | PBS with 0.02% sodium azide and 50% glycerol{{ptg:BufferTemp}}7.3 |
| Storage Conditions | Store at -20°C. Stable for one year after shipment. Aliquoting is unnecessary for -20oC storage. |
Background Information
The Aspergillus nidulans 'never in mitosis A' (NIMA) is a serine/ threonine kinase that controls initiation of mitosis, whereas its inactivation is necessary for mitotic exit. NIMA-related kinases (NEKs) are a group of protein kinases that are homologous to NIMA. Evidence suggests that NEKs perform functions similar to those of NIMA. Human NIMA-related kinase 6 (NEK6, synonym: SID6-1512) is comprised of 338 amino acids and shows both nuclear and cytoplasmic localizations in HeLa cells. NEK6 is required for mitotic progression of human cells. NEK6 is phosphorylated and activated during M phase. Inhibition of Nek6 function by either overexpression of an inactive Nek6 mutant or elimination of endogenous Nek6 by siRNA arrests cells in M phase and triggers apoptosis. Recombinant human NEK6 protein produced in insect cells effectively phosphorylates histones H1 and H3, but not casein. Thus, these results suggest that, unlike other mammalian NIMA-related kinases, NEK6 is a mitotic histone kinase which regulates chromatin condensation in mammalian cells. NEK6 transcripts are ubiquitously expressed with the highest expression found in the heart and skeletal muscle, and the hNek6 gene is localized to human chromosome 9q33-34. NEK6 has four isoforms with MW 35-40 kDa.
Protocols
| Product Specific Protocols | |
|---|---|
| IF protocol for NEK6 antibody 28070-1-AP | Download protocol |
| IHC protocol for NEK6 antibody 28070-1-AP | Download protocol |
| WB protocol for NEK6 antibody 28070-1-AP | Download protocol |
| Standard Protocols | |
|---|---|
| Click here to view our Standard Protocols |